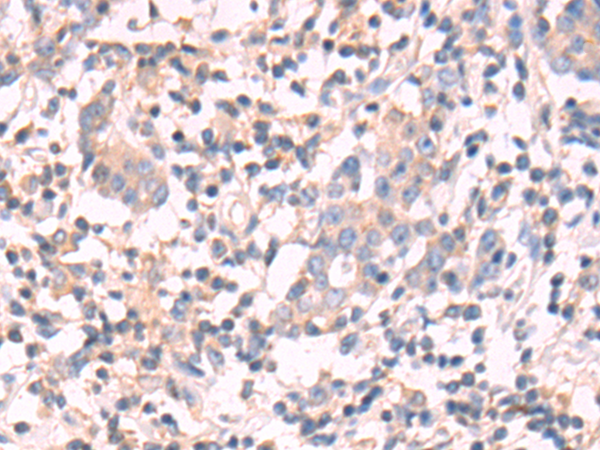

DNAJC11 Rabbit Polyclonal Antibody
CAT#: TA370963S
DNAJC11 rabbit polyclonal antibody
Size: 100 ul
Need it in bulk or conjugated?
Get a free quote
CNY 800.00
CNY 1280.00
CNY 300.00
CNY 1430.00
Specifications
| Product Data | |
| Applications | IHC, WB |
| Recommend Dilution | WB: 500-2000 WB positive control: K562 cell lysate IHC: 50-100 Positive control: Human prostate cancer Predicted cell location: Cytoplasm |
| Reactivity | Human, Mouse |
| Host | Rabbit |
| Clonality | Polyclonal |
| Immunogen | Fusion protein of human DNAJC11 |
| Isotype | IgG |
| Formulation | pH7.4 PBS, 0.05% NaN3, 40% Glycerol |
| Purification | Antigen affinity purification |
| Conjugation | Unconjugated |
| Storage Condition | Store at -20°C. |
| Predicted Protein Size | 63 kDa |
| Gene Name | DnaJ heat shock protein family (Hsp40) member C11 |
| Database Link | |
| Background | Required for mitochondrial inner membrane organization. Seems to function through its association with the MICOS complex and the mitochondrial outer membrane sorting assembly machinery (SAM) complex. |
| Synonyms | dJ126A5.1; FLJ10737 |
| Reference Data | |
Documents
| Product Manuals |
| FAQs |
| SDS |
Resources
| 抗体相关资料 |
其它DNAJC11产品